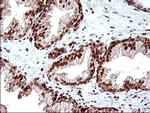
POLR3GL Antibody in Immunohistochemistry (Paraffin) (IHC (P))
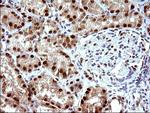
POLR3GL Antibody in Immunohistochemistry (Paraffin) (IHC (P))

Search
OriGene
POLR3GL Monoclonal Antibody (OTI5E8), TrueMAB™
{{$productOrderCtrl.translations['antibody.pdp.commerceCard.promotion.promotions']}}
{{$productOrderCtrl.translations['antibody.pdp.commerceCard.promotion.viewpromo']}}
{{$productOrderCtrl.translations['antibody.pdp.commerceCard.promotion.promocode']}}: {{promo.promoCode}} {{promo.promoTitle}} {{promo.promoDescription}}. {{$productOrderCtrl.translations['antibody.pdp.commerceCard.promotion.learnmore']}}
产品信息
TA506865
种属反应
宿主/亚型
分类
类型
克隆号
抗原
偶联物
形式
浓度
规格
纯化类型
保存液
内含物
保存条件
运输条件
靶标信息
DNA-dependent RNA polymerase catalyzes the transcription of DNA into RNA using the four ribonucleoside triphosphates as substrates. Specific peripheric component of RNA polymerase III which synthesizes small RNAs, such as 5S rRNA and tRNAs.
仅用于科研。不用于诊断过程。未经明确授权不得转售。
篇参考文献 (0)
生物信息学
蛋白别名: alternative RNA polymerase III subunit 32; DNA-directed RNA polymerase III subunit G-like; DNA-directed RNA polymerase III subunit RPC7-like; polymerase (RNA) III (DNA directed) polypeptide G (32kD)-like; polymerase (RNA) III subunit G like; RNA polymerase III 32 kDa beta subunit; RNA polymerase III subunit C7-like; RNA polymerase III subunit G like; RPC32-beta; RPC32-like protein; unnamed protein product
基因别名: flj32422; POLR3GL; RPC32HOM; SOFM
UniProt ID: (Human) Q9BT43
Entrez Gene ID: (Human) 84265